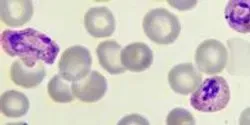

All by University of California - San Francisco
Filter by
AllArticlesAudioEbooksEventsInfographicsNewsProductsSurveysDocumentsVideosVirtual EventsWebinars
UC San Francisco study suggests healthy diet, sleep and exercise can mitigate negative impacts of stress.
| 3 min read

As the University of California, San Francisco confronts a continued changing landscape, the UCSF community will likely face cultural and organizational changes that are necessary to support effective, nimble decisions that align strategy with spending priorities.
| 4 min read

UC San Francisco’s four professional schools topped the nation in federal research funding in 2013, with the University as a whole ranking first among public recipients and second overall in funds from the National Institutes of Health (NIH), according to annual NIH figures.
| 3 min read

Vitamin C affects whether genes are switched on or off inside mouse stem cells, suggesting that it could may play a fundamental role in helping to guide normal development in mice, humans and other animals, a team led by UC San Francisco researchers has discovered.
| 4 min read